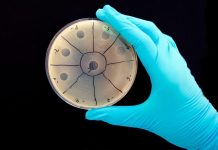
Вчені хочуть замінити антибіотики програмованими вірусами

У США прогнозують сценарій загибелі 2 млн чоловік від коронавірусу
Координатор Білого дому Дебора Біркс, що займається питаннями запобігання поширенню коронавіруса, закликала переглянути сумний сценарій з 2 млн загиблими. Реальне число смертей виявилося набагато...
Медики назвали продукти, які допомагають протистояти зараженню коронавірусу
Зарубіжний медики розповіли, чи допомагає дієта протистояти зараженню коронавірусу. Матеріал відповідного змісту представило видання Deutsche Fillet.
Стрімке поширення коронавіруса по всьому світу триває, в даний...
Нейромережа знайшла препарати, які можуть блокувати розмноження коронавірусу
Штучний інтелект виявив 10 препаратів для зупинки розмноження коронавірусу нового типу в людських клітинах. Про це пише прес-служба компанії-розробника нейромережі, біологічного стартапу Gero.
Штучний інтелект...
Опубліковано відео з ураженням легень коронавірусом
Співробітниками лікарні Університету Джорджа Вашингтона було опубліковано відео з ураженням легень коронавірусом. Повідомляється, що для того, щоб реалізувати 3D-модель фахівці скористалися рентгенографією реальної людини.
https://twitter.com/ABC7HeatherGraf/status/1242256426967408640?ref_src=twsrc%5Etfw%7Ctwcamp%5Etweetembed&ref_url=http%3A%2F%2Fwjla.com%2Fnews%2Flocal%2Fa-new-perspective-virtual-reality-shows-exactly-how-covid-19-can-damage-the-lungs
Так,...
Вчені визначили найбільш заразний період для коронавірусної інфекції
Вчені визначили найбільш заразний період для коронавірусної інфекції. Тобто період після інфікування, коли носій вірусу становить найбільшу небезпеку для оточуючих.
Наукову статтю про це опублікували в авторитетному...
Експерти оцінили ймовірність передачі коронавіруса через їжу
Експерти оцінили ризик зараження коронавірусом через їжу. Питання мучить багатьох людей на тлі ажіотажу в продуктових магазинах.
Професор Бенджамін Чепмен з Університету Північної Кароліни розповів,...
Чому коронавірус найсильніше вдарив по Італії
Звідусіль сипляться найдивовижніші версії того, чому саме північ Італії так постраждав. Наприклад, деякі місцеві блогери чомусь вирішили, що спалах в Бергамо пов'язаний з плановою вакцинацією для людей похилого...
У Німеччині до наступної весни продовжать надзвичайний стан через коронавірус
У бундестазі відбулося позачергове засідання з порядком денним "Подолання кризи коронавіруса". Більшість парламентаріїв погодилися, що надзвичайну епідеміологічну ситуацію в Німеччині слід продовжити до 1...
Вчені встановили практично невразливу для коронавіруса категорію людей
Вчені проаналізували звіт про випадки зараження коронавірусом, підготовлений центром з контролю і профілактиці захворювань Китаю, і знайшли категорію людей, яка найрідше заражається COVID-19.
Згідно зафіксованим...
Вчені хочуть замінити антибіотики програмованими вірусами
Вчені з компанії Felix хочуть замінити антибіотики програмованими вірусами, які здатні «заражати» бактерії. Це допоможе вирішити проблему стійкості до антибіотиків.
Співзасновник стартапу Felix Роберт Макбрайд пояснив, що ця...